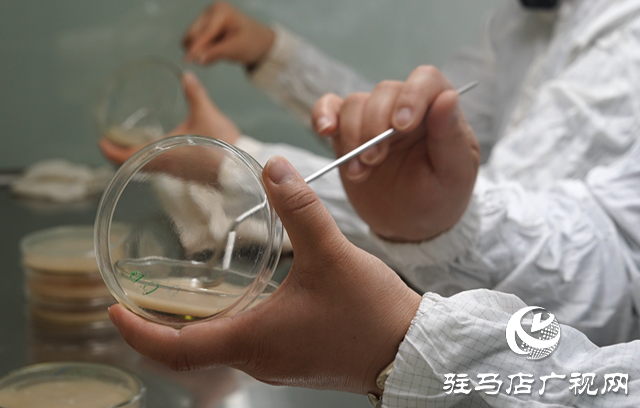

点击量:2342
全媒体记者 张洋 苏磊
有这样一个团队,巾帼不让须眉,在菌种选育、菌种保藏、工艺研究项目攻关中,实现一个又一个突破,展示出职场女性的飒爽英姿。她们就是天方药业有限公司原料药分厂408车间菌种工艺班组。

天方药业有限公司原料药分厂408车间菌种工艺班组共16人,其中女职工15人,是欧典螺旋霉素菌种选育培养的源头,培育的菌种质量关系到产品总体质量。为此,她们不断提高学习能力,把理论和知识转化为生产力和创造力。
408车间工艺分析班班长李爱玲告诉记者,作为菌种工艺班组人员,他们始终坚持问题导向,努力提高自己工艺控制的预见性、敏感性、全局性,认真做好安全生产工作,在工作之余,不断学习发酵生产知识,发挥女职工认真心细的优势,在劳动生产中发挥半边天作用。
班组全员凭着对工作的热爱,不断追求新知识,进行自我更新与完善;积极研究菌种的选育方法,工作时保持高度的无菌意识,确保供种率100%,染菌率为零。

“原料药生产中,无菌操作是最为关键的一步。先从菌种选育开始、到种子的扩大培养,如果其中某一步出现偏差,将会对种子造成灾难性的后果。”408车间菌种班班长罗亚玲说,菌种是核心,菌种操作需要的环境非常苛刻,洁净度一定要达到要求,在清洁过程中需要对房间的顶棚、墙壁进行无死角、全方位的清扫、清洁、消毒,每周还会对洁净区进行臭氧消毒,才能使工作台和房间正常使用。
在全体人员的共同努力下,协助车间顺利通过2012、2015、2018年欧盟审计。408车间生产的欧典螺旋霉素年产值约1.6亿元,100%出口国外市场,产品合格率100%,没有出现任何质量投诉。
天方药业有限公司四分厂408车间党支部书记兼车间主任王文表示,爱岗敬业、乐于奉献是菌种工艺班组人员的写照。班组中有朝气蓬勃的零零后,也有默默无闻工作30年的老大姐,他们始终不忘初心和梦想,在平凡的工作岗位上认真工作、精诚合作,绽放一线巾帼员工的绚丽风采。
目前,408车间菌种工艺班组正在全面梳理软件、硬件,为下次欧盟认证做好充分准备。她们班组也在今年“三八”妇女节期间,获得驻马店市巾帼文明岗称号。(编辑 詹云清)
免责声明:凡本网注明“来源:XXX(非驻马店广视网、驻马店融媒、驻马店网络问政、掌上驻马店、驻马店头条、驻马店广播电视台)”的作品,均转载自其它媒体,转载目的在于传递更多信息,并不代表本网赞同其观点和对其真实性负责,作品版权归原作者所有,如有侵犯您的原创版权请告知,我们将尽快删除相关内容。凡是本网原创的作品,拒绝任何不保留版权的转载,如需转载请标注来源并添加本文链接,否则承担相应法律后果。
来源 / 驻马店广视网
责任编辑 / 詹云清
审核 / 李俊杰 刘晓明
终审 / 平筠
上一篇:梅花绽放春意浓 踏青赏花正当时